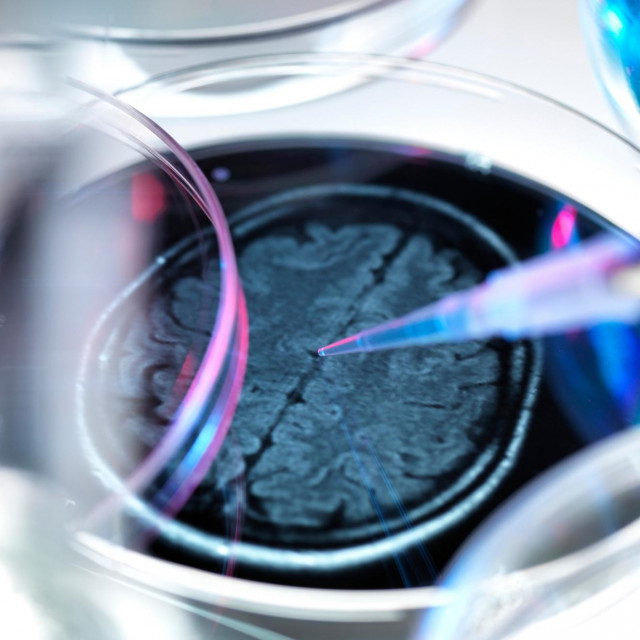
Ilustracija

Mozak se može natjerati da se 'teleportira' pomoću lasera, pokazalo je novo istraživanje, u sklopu kojega su znanstvenici ustanovili da su u mogućnosti kontrolirati naš 'unutarnji GPS', piše Yahoo News.
Laserske zrake mogu se usmjeriti u hipokampus, područje odgovorno za pamćenje i učenje, kako bi se stimulirali neuroni zvani 'stanice mjesta', otkrivaju revolucionarna istraživanja na miševima.
Stanice mjesta aktiviraju se kada uđemo u novo okruženje i pohranimo to mjesto u svoje sjećanje.
Poticanjem stanica koje se ne podudaraju s našim trenutnim okolišem, možemo se 'mentalno teleportirati' do mjesta na koje su te stanice povezane u memoriji.
Ovo je prva studija koja je pokazala da aktivnost stanica mjesta stoji iza sposobnosti mozga da dohvaća pamćenje i njime navigira.
N...

Za sudjelovanje u komentarima je potrebna prijava, odnosno registracija ako još nemaš korisnički profil....